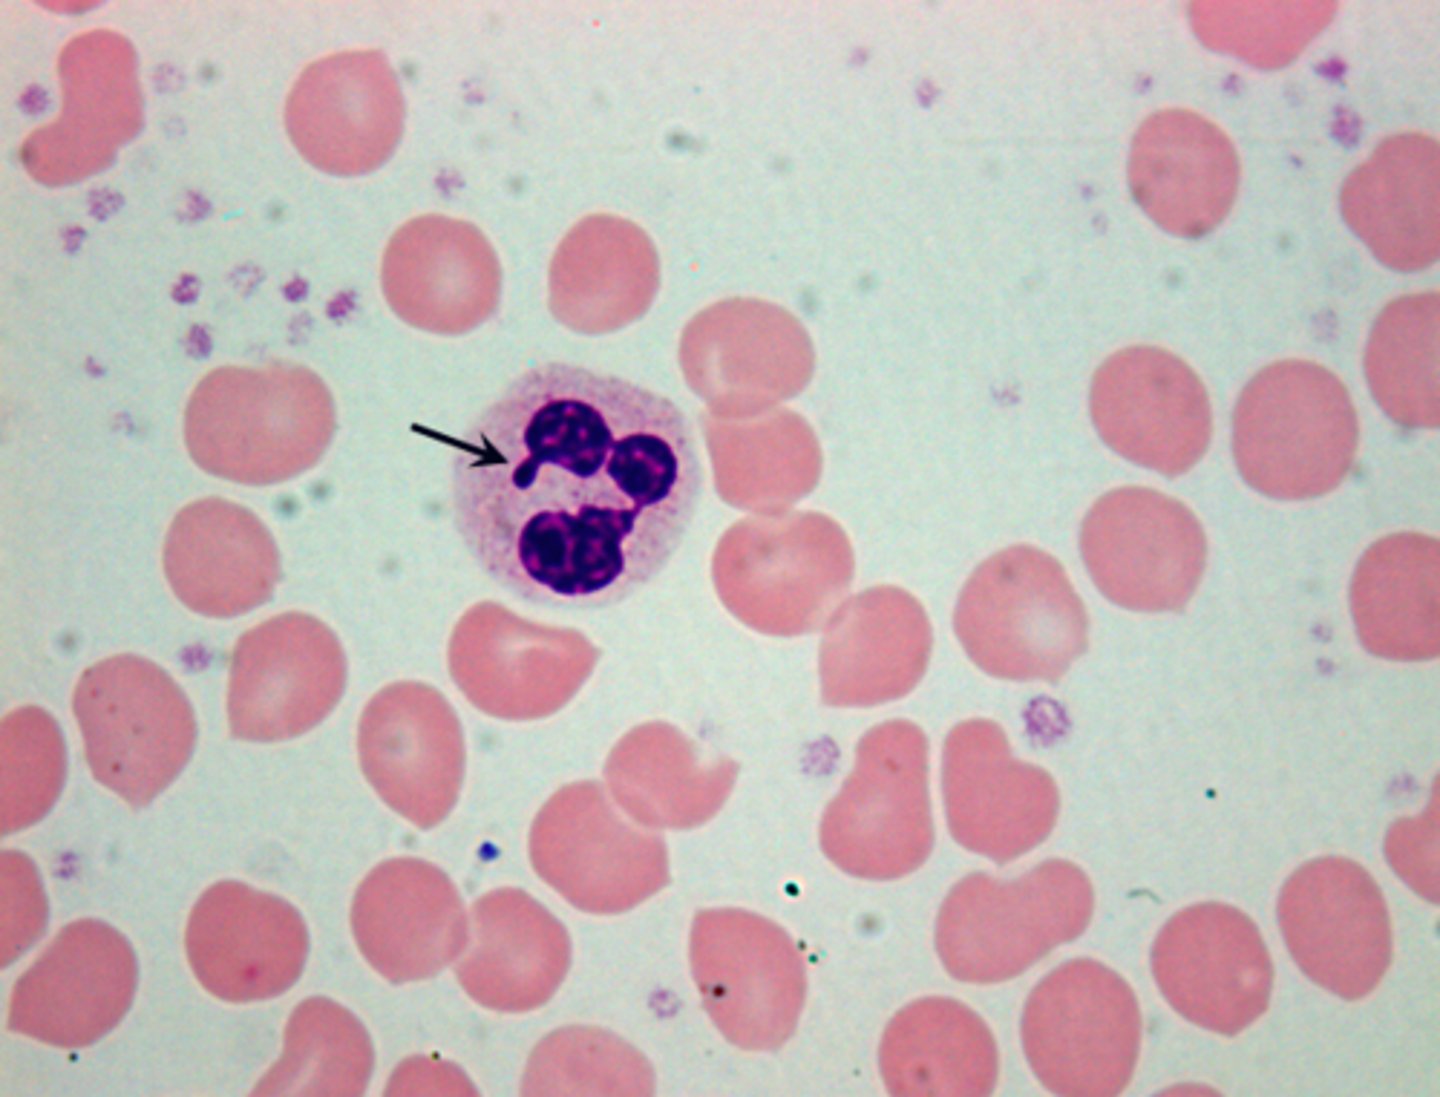
<p>Barr body</p>
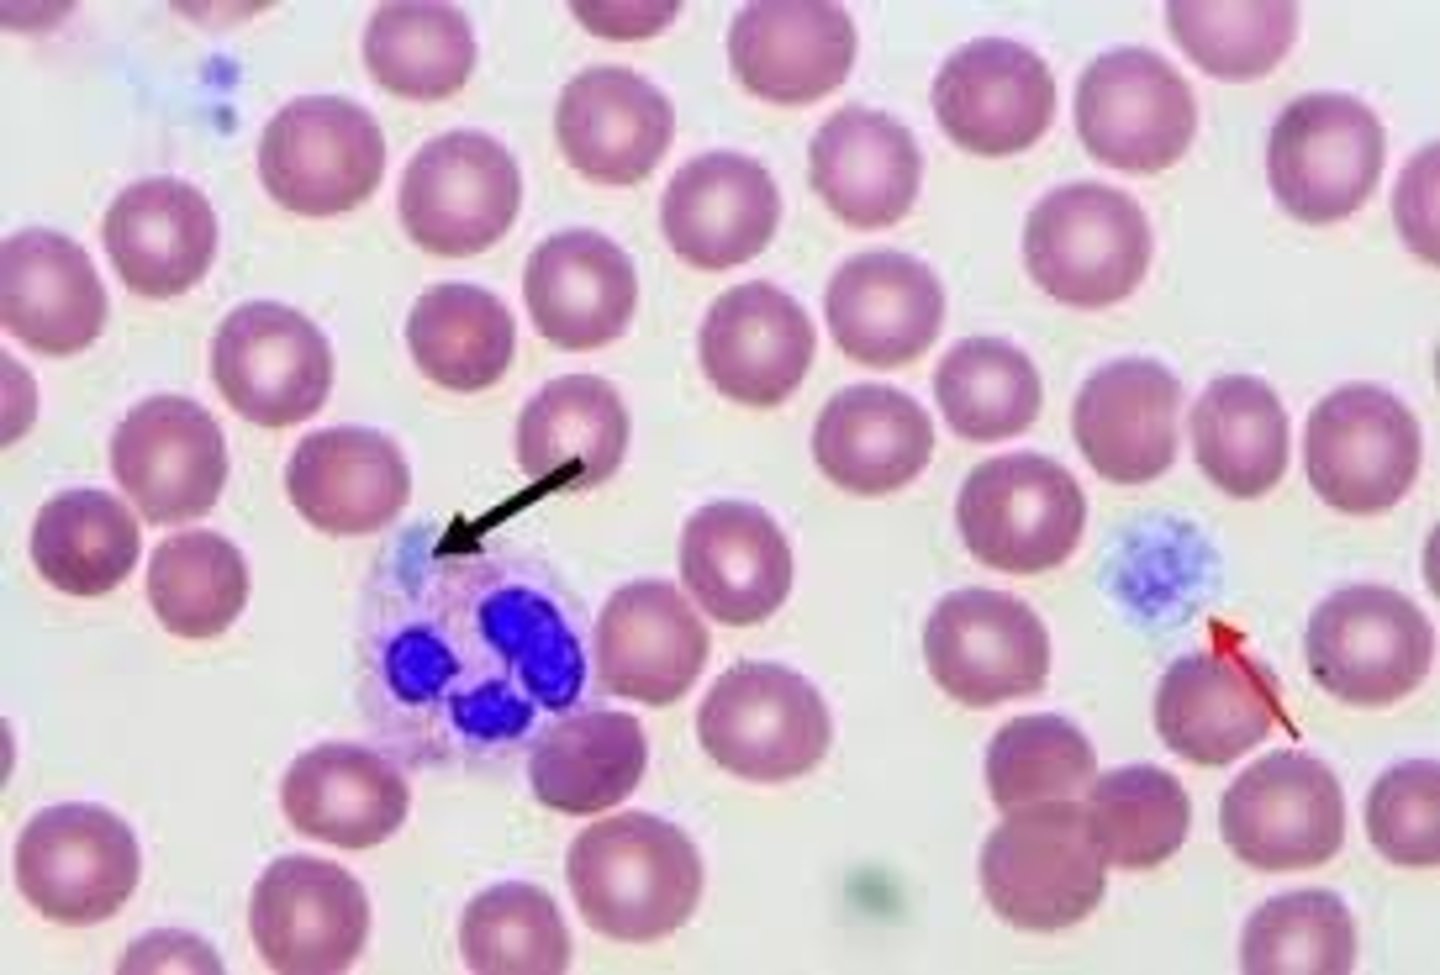
<p>Giant platelets, large dohle body like inclusions within neutrophils, eosinophils, basophils, and monocytes</p>
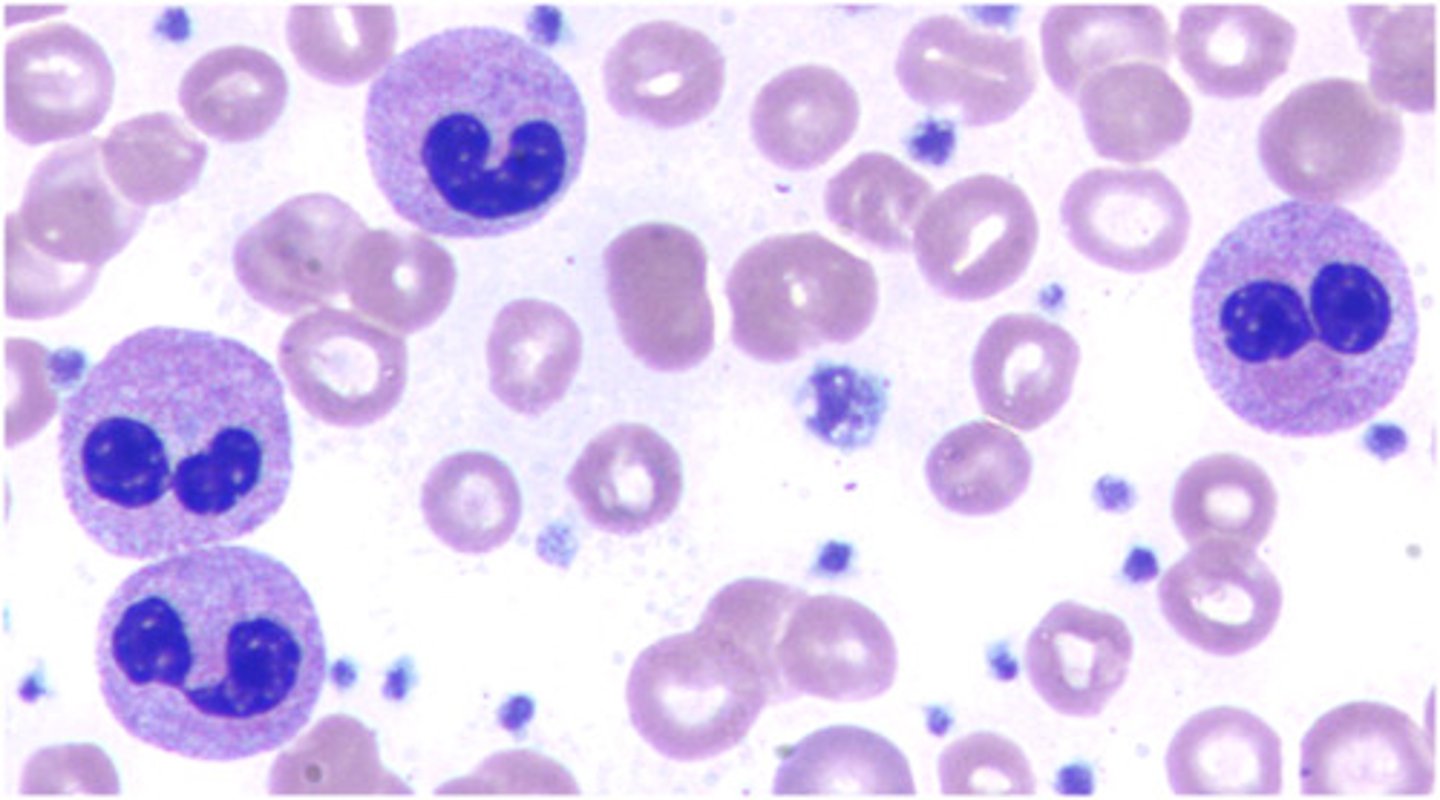
<p>Hyposegmented neutrophils (dumbell shape)</p>
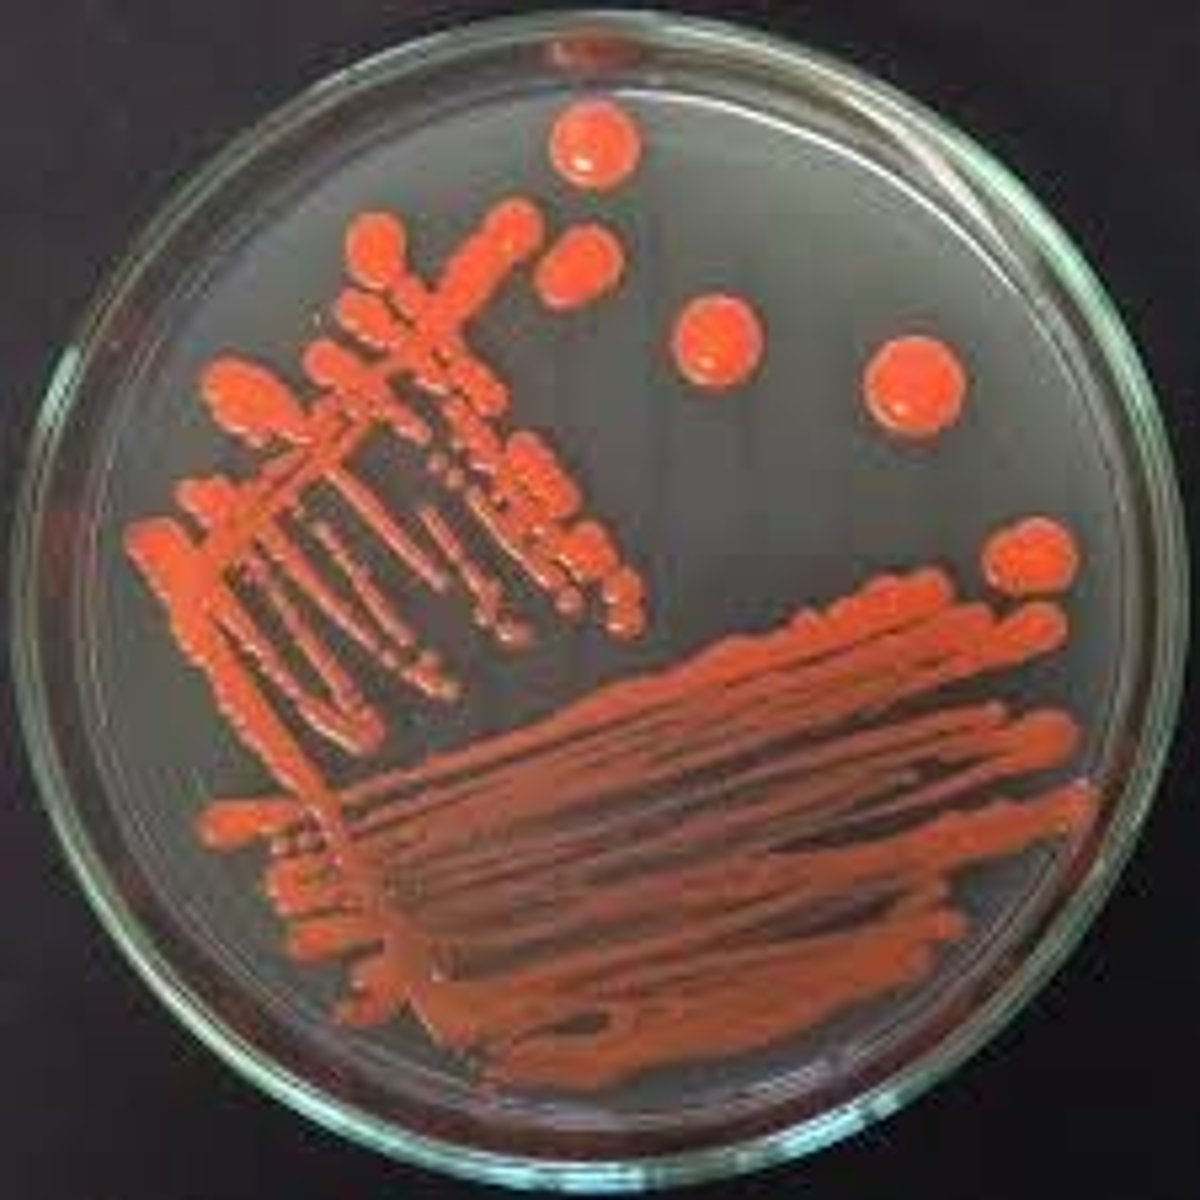
<p>Rhodotorula spp.</p>

1/435
Looks like no tags are added yet.
Name | Mastery | Learn | Test | Matching | Spaced | Call with Kai |
|---|
No analytics yet
Send a link to your students to track their progress
FFP used for
Multiple coagulation deficiencies
Factor XI deficiency
Cryoprecipitate used for
Replace fibrinogen loss due to DIC
Massive bleeding
Dysfibrinogenemia with active bleeding
Plateletpheresis preparation steps
Light spin (remove RBC)
Heavy spin (spin down PLT and WBC)
Supernatant goes into bag for freezing (FFP)
Remaining plasma, platelets, and WBC = platelets
Irradiated blood prevents
GVHD
Also used for cancer patients, or patients who are immunocompromised
Leukocyte reduced blood prevents
Febrile nonhemolytic transfusion reactions (FNHTRs)
Blood generally kept at what temperature?
1-10C
Platelets and granulocytes kept at what temperature?
20-24C
Platelets usually kept on agitator to ensure that the platelets are continuously oxygenated
ACD, CPD, CPD2 expiration
21 days
CPDA-1 expiration
35 days
Rouleaux resolution
Saline wash and repeat
Common IgM antibodies in blood bank (Cold)
anti-I, H, M, N, P1, Lea, Leb
Common IgG antibodies in blood bank (Warm)
anti-D, C, c, E, e, M (some), K, k, Fya, Fyb, Jka, Jkb
Antibodies enhanced by enzyme panel
RhIp Lewis the Kidd
Rh, I, Lea, Leb, Jka, Jkb
Overproduction of IgM associated with
Waldenstrom's Primary Macroglobulinemia
Overproduction of IgG associated with
Multiple Myeloma
Serum calcitonin elevated in
Medullary carcinoma of thryroid
Normal myeloid:erythroid ratio
2:1 to 4:1
Centromere ANA pattern
CREST syndrome
Homogeneous or speckled ANA pattern
SLE
Speckeled ANA pattern
RA or Sjorgen's
Measurement of sodium/chloride in sweat is useful test for
Cystic Fibrosis

Analytes increased due to delay in centrifugation
AST, ALT, Potassium, Creatinine
Analytes decreased due to delay in centrifugation
Glucose, ionized calcium, bicarbonate, folate
Reducing sugars include
Lactose, glucose, ribose
Incorporation of sulfamethoxazole and trimethoprim in culture media enhance recovery of
Strep. pyogenes
Longer staining times associated with which type of smear
Bone marrow smear
Dosage associated with homozygous or heterozygous cells
Homozygous
Confirmatory test for syphilis
FTA-ABS (fluorescent treponemal antibody absorption test)
VRDL and RPR are utilize which type of methodology
Flocculation
Mycobacterium species positive for nitrate reduction
Mycobacterium tuberculosis
Measles (rubella), mumps, polio vaccine deferral time period
2 weeks
Burkitt's lymphoma
8:14 translocation; associated with EBV; "starry sky" appearance on histology

Hodgkin Lymphoma (HL)
is a malignant lymphoma
Reed Sternberg cells are the hallmark of HL. Enlarged, painless lymph node in the neck (often the first sign of HL).

A defective clot retraction might be caused by
Lack of defect of platelet receptor IIb/IIIa
German measles vaccine deferral time period
4 weeks
This protozoa can be routinely cultured
Acanthamoeba spp.

Aspirin prevent synthesis of
Thromboxane A2
Mycobacterium spp whose colonies are photochromogenic
Mycobacterium kansaii
Burkholderia cepacia
GNB that is motile with polar tufts of flagella and produces yellow pigment
Oxidase (+)
Pyocyanin (-)
Arginine dihydrolase (-)
Known to cause fulminating lung infections in CF patients
Burkholderia mallei
Glander's disease
forms nodular lesions in the lung tissue and can cause ulcers leading to sepsis and death.
Clenched fist cellulitis associated with what organism
Eikenella corrodens

CEA tumor marker
colorectal cancer
Intestinal amebiasis symptoms
Abdominal cramps
Fever
Diarrhea
Bloody stool
Type of anemia where inability to incorporate iron into protoporphyrin ring
Sideroblastic anemia
Immunoassay for hCG uses which subunit of hCG
Beta
Parasite typically comes from cat feces
Toxoplasma gondii

This condition made up of small clots made of platelets and large forms of VWF
TTP (thrombotic thrombocytopenic purpura)
Normal heme contains
Four heme and four globin chains

Detection of MRSA
Zone of <10mm with an oxacillin disk on MH agar
Molecular tests for mecA gene
Drug of choice for Clostridium difficile and MRSA
Vancomycin (glycopeptide, inhibit cell wall synthesis)
Drugs of choice for pseudomonas aeruginosa and other aerobes
Ciprofloxacin, Norfloxacin (quinolines, inhibit nucleic acid synthesis)
Drug of choice for UTI, enteric infections
Sulfamethoxazole (Sulfonomides, analogue of PABA)
Extended-spectrum beta-lactamases
Enzymes that give bacteria immunity to both penicillin and cephalosporin antibiotics
Tiny GN coccobacilli associated with wild boar
Brucella spp.

This condition is associated with oligoclonal band in CSF electrophoresis
Multiple sclerosis
Cell indicative of kidney disease
Tubular epithelial cells

Species-specific genes for MRSA
16S and 23S ribosomal RNA genes
DNA gyrase (gyrA)
Superoxide dismutase (sodA)
UA findings associated with nephrotic syndrome
Oval fat bodies
Fatty and waxy casts
Renal tubular epithelial cells
Heavy proteinuria
Foamy appearance
Follow up tests for speckled ANA patterns
Smith antibodies
SS-A/SS-b+ antibodies
Microorganism associated with tinea cruris AKA jock itch
Epidermophyton floccosum

Inactive X-chromosome in the somatic cells of mammalian females that appear as nuclear appendages
Barr body
Deferral time for terminated pregnancy in the 3rd trimester
6 weeks
Overproduced IgM associated with
Waldenstrom's disease
Common cause of atrophic rhinitis
Klebsiella ozaenae
Clinical symptoms of nephrotic syndrome
Swelling
Weight gain from fluid retention
Poor appetite
High BP
Confirmatory test for circulating lupus anticoagulant
Platelet neutralization test
This sexually transmitted parasite displays symptoms in women but men are frequently asymptomatic
4 anterior flagella and granules along its axostyle
Trichomonas vaginalis

Hypersegmented neutrophils associated with
Megaloblastic anemia which is commonly caused by vitamin B12 deficiency

Hemosiderin-laden macrophages in CSF sample associated with
Intracranial hemorrhage
Washed RBC will decrease/prevent which type of RBC transfusion reaction
Allergic reaction
Washing cells removes excess plasma proteins
This organism has dark septate hyphae, large conidia and typically contain 4 cells
Curvularia spp.

Alternaria sp.
CHAINED poroconidia HORIZONTAL and VERTICAL SEPTA
CLUB shaped bases

ADAMSTS13
Cleaves multimers of vWF from multimers into monomers
Lack of causes TTP
Deficiency is either genetic or more commonly: Produce autoantibody
Adult female with autoantibody

Atypical RBCs associated with post-splenectomy
Acanthocytes
Echinocytes
Codocytes
Spherocytes
Schistocytes
Howell-Jolly bodies
Dubin-Johnson syndrome
autosomal recessive, conj hyperbilirubinemia, defect in bili transport, black color to liver p239

Organisms known to cause bacterial vaginosis
Mobiluncus spp
Gardnerella vaginalis
Rapidly progressive fungal infection of the sinuses in immunosuppressed or diabetic patients
Phycomycosis
Neoplastic T lymphocytes that have irregular, convoluted (cerebriform) nuclear outlines
Sezary cells

This Pseudomonas spp produces pyocyanin
Pseudomonas aeruginosa

Electrolyte panel tests
Sodium
Potassium
Chloride
CO2
Hallmark of May-Hegglin anomaly
Giant platelets, large dohle body like inclusions within neutrophils, eosinophils, basophils, and monocytes
Hallmark of Pelger-Huet anomaly
Hyposegmented neutrophils (dumbell shape)
Alder-Reilly Anomaly
Inability to degrade mucopolysaccharides results in accumulation of lipids
On a slide, every leukocyte seen exhibits dense, basophilic coarse granulation
This organism is endemic in Southern and Central California
Growth of 2-21 days
Coccidioides immitis

Cause of tularemia
Francisella spp.

Poikilocytosis
Variation in shape
Anisocytosis
Variation in size
Activation unit in classical complement pathway
C4, C2, C3
Urea nitrogen RR
6-20 mg/dL
Creatinine RR
0.6-1.2 mg/dL
This malarial parasite presents reticulocytes with Schuffner's dots
Plasmodium vivax

Platelet satellitism can be result of blood collection in which type of tube
EDTA (purple top)
What chromosome is alpha chain globin coded on
Chromosome 16
What chromosome is beta chain globin coded on
Chromosome 11
Method for long-term diabetic monitoring in SS patients
Fructosamine
This organism is normal flora of skin, cause of opportunistic mycoses in immunocompromised patients
Pink pigment is hallmark characteristic
Rhodotorula spp.
Common cause of septic arthritis in patients <30y
Neisseria gonorrhoeae

This adsorption technique removes cold Ab such as anti-I
Rabbit erythrocyte stroma (RESt)
I RESt
This plasmodium spp. contains 6 to 12 merozoites
Plasmodium malariae

This biomarker is regulator of myocyte contraction
cTnT